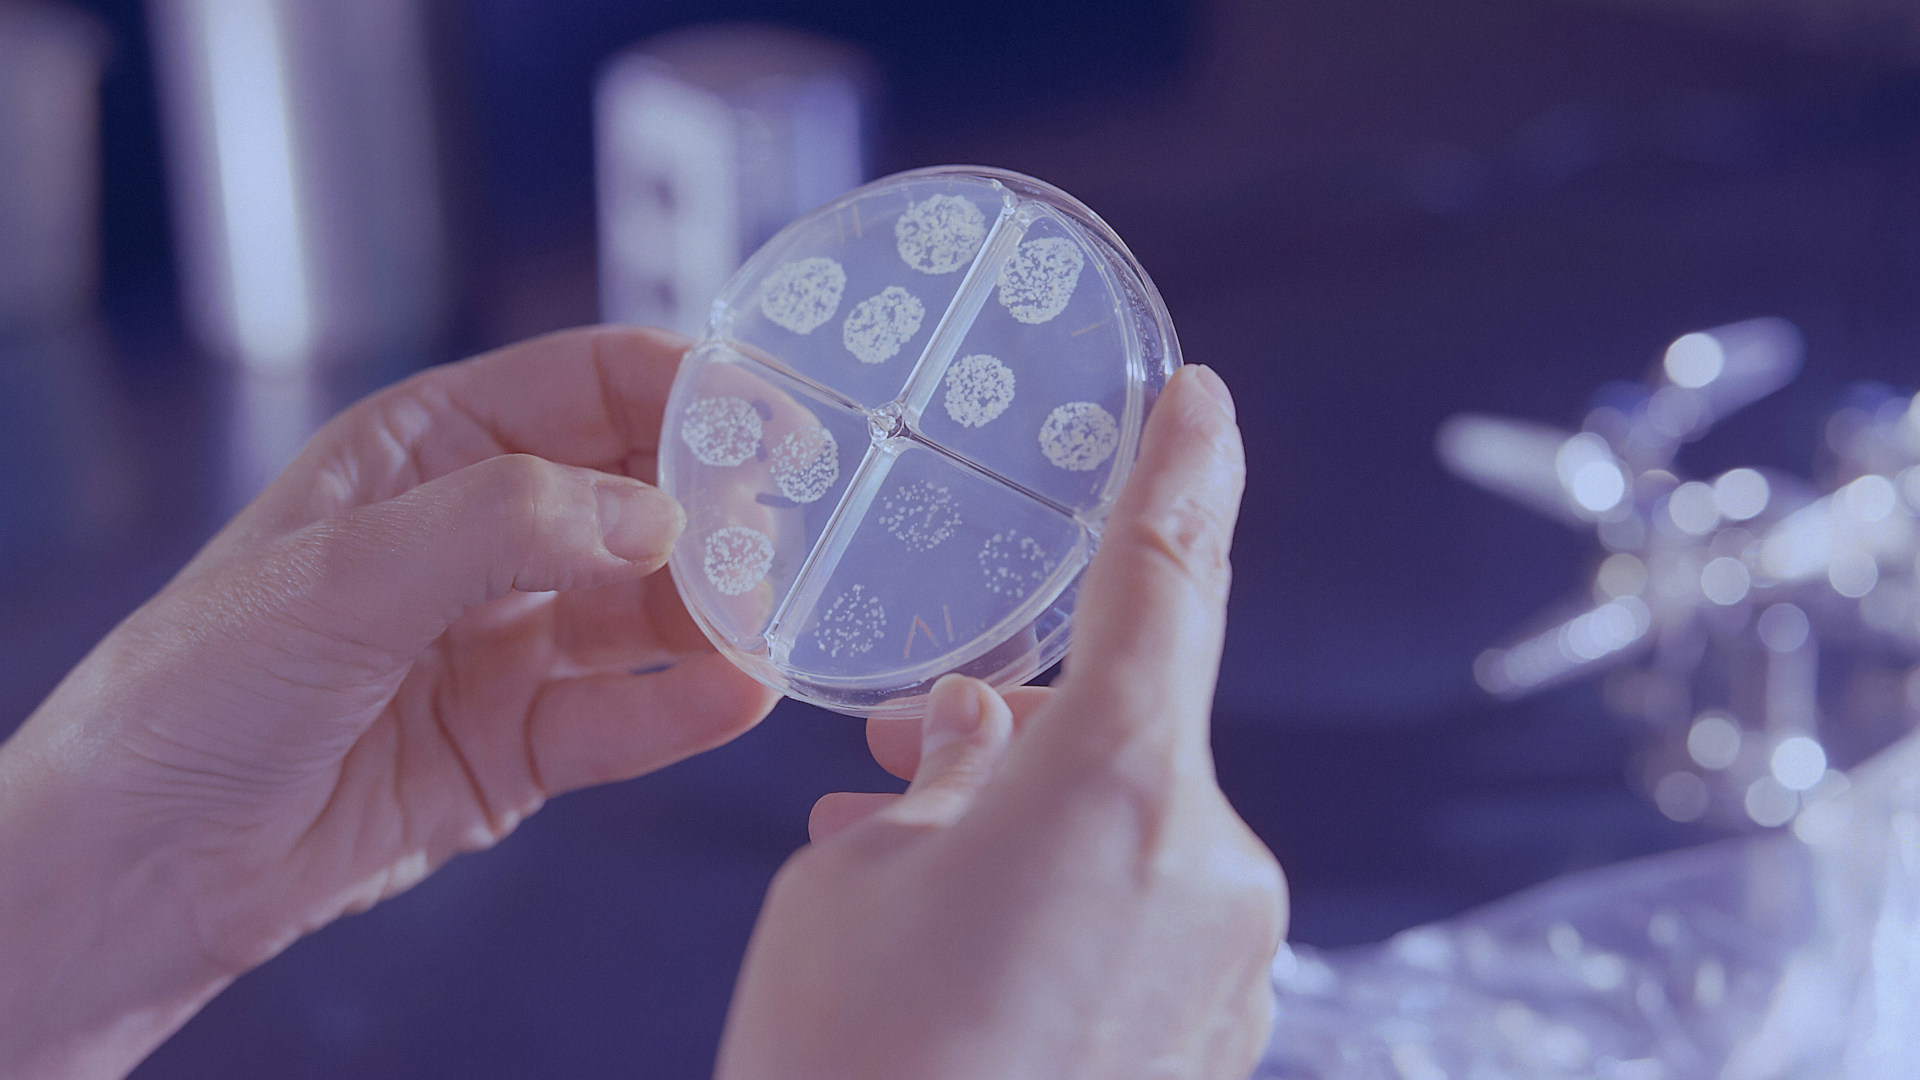

Trending Articles
See the features, reviews, and essays that are currently popular with Undark’s readers.

What the Anti-Sunscreen Movement Misses
01

Reflecting on the ‘Crime Gene’ Conference, 30 Years Later
02

Book Review: The Mixed Blessing of Antibiotics
03

Will Science Journalism Funders Step Up or Retreat?
04

EPA Readied a Report on One Forever Chemical. Now It’s in Limbo.
05